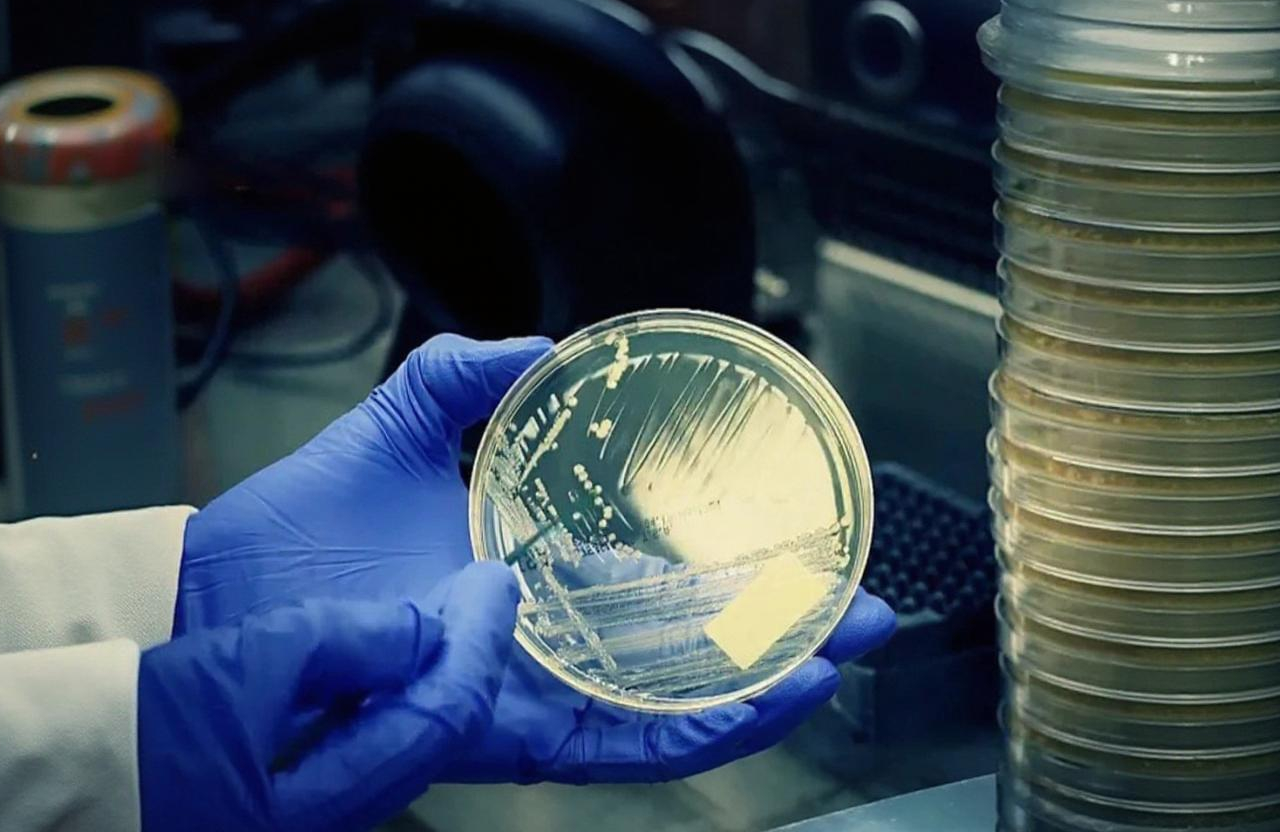
The Microbial Enumeration Test

The Microbial Enumeration Test
The Microbial Enumeration Test is a crucial quantitative method used to determine the total number of viable microorganisms in a sample.
List of Microorganisms Used in Enumeration
General Microbial Groups:
- Total Aerobic Microbial Count (TAMC) – general bacteria
- Total Yeast and Mold Count (TYMC) – fungi
Bacteria:
Escherichia coli, Salmonella spp., Pseudomonas aeruginosa, Staphylococcus aureus, Bacillus cereus, Listeria monocytogenes, Clostridium perfringens, Enterobacteriaceae (family level group), Coliforms (including E. coli) – indicator organisms, Bile-tolerant Gram-negative bacteria, Lactic acid bacteria
For enumeration of specific microorganisms not listed, please contact us